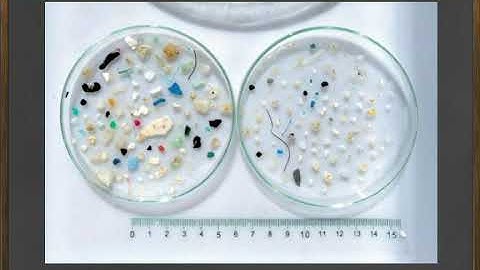
EcC3.4 Plastic

⬇ DOWNLOAD NOW
Kalau muncul iklan pop-up, tutup lalu klik tombol kembali
Download lagu PRAKTIKUM CSS3 BAGIAN 1 MODUL3 4 secara gratis hanya untuk keperluan promosi. Dukung artis favorit kamu dengan membeli musik original di iTunes atau platform resmi lainnya.
 MODUL 3 PRAKTIKUM CSS3 BAGIAN 1
MODUL 3 PRAKTIKUM CSS3 BAGIAN 1
 0324 video kampagne v4 ae 1
0324 video kampagne v4 ae 1
 2023 06 21 UL4600 3rd Edition
2023 06 21 UL4600 3rd Edition
 Movie_S3.mp4
Movie_S3.mp4
 U4 L3 Culture video
U4 L3 Culture video
 Practical exercise 4 | 44/170 | UPV
Practical exercise 4 | 44/170 | UPV
EcC3.4 Plastic
EcC3.4 Plastic
 EDUC4703 VidClip 4.3 2013
EDUC4703 VidClip 4.3 2013